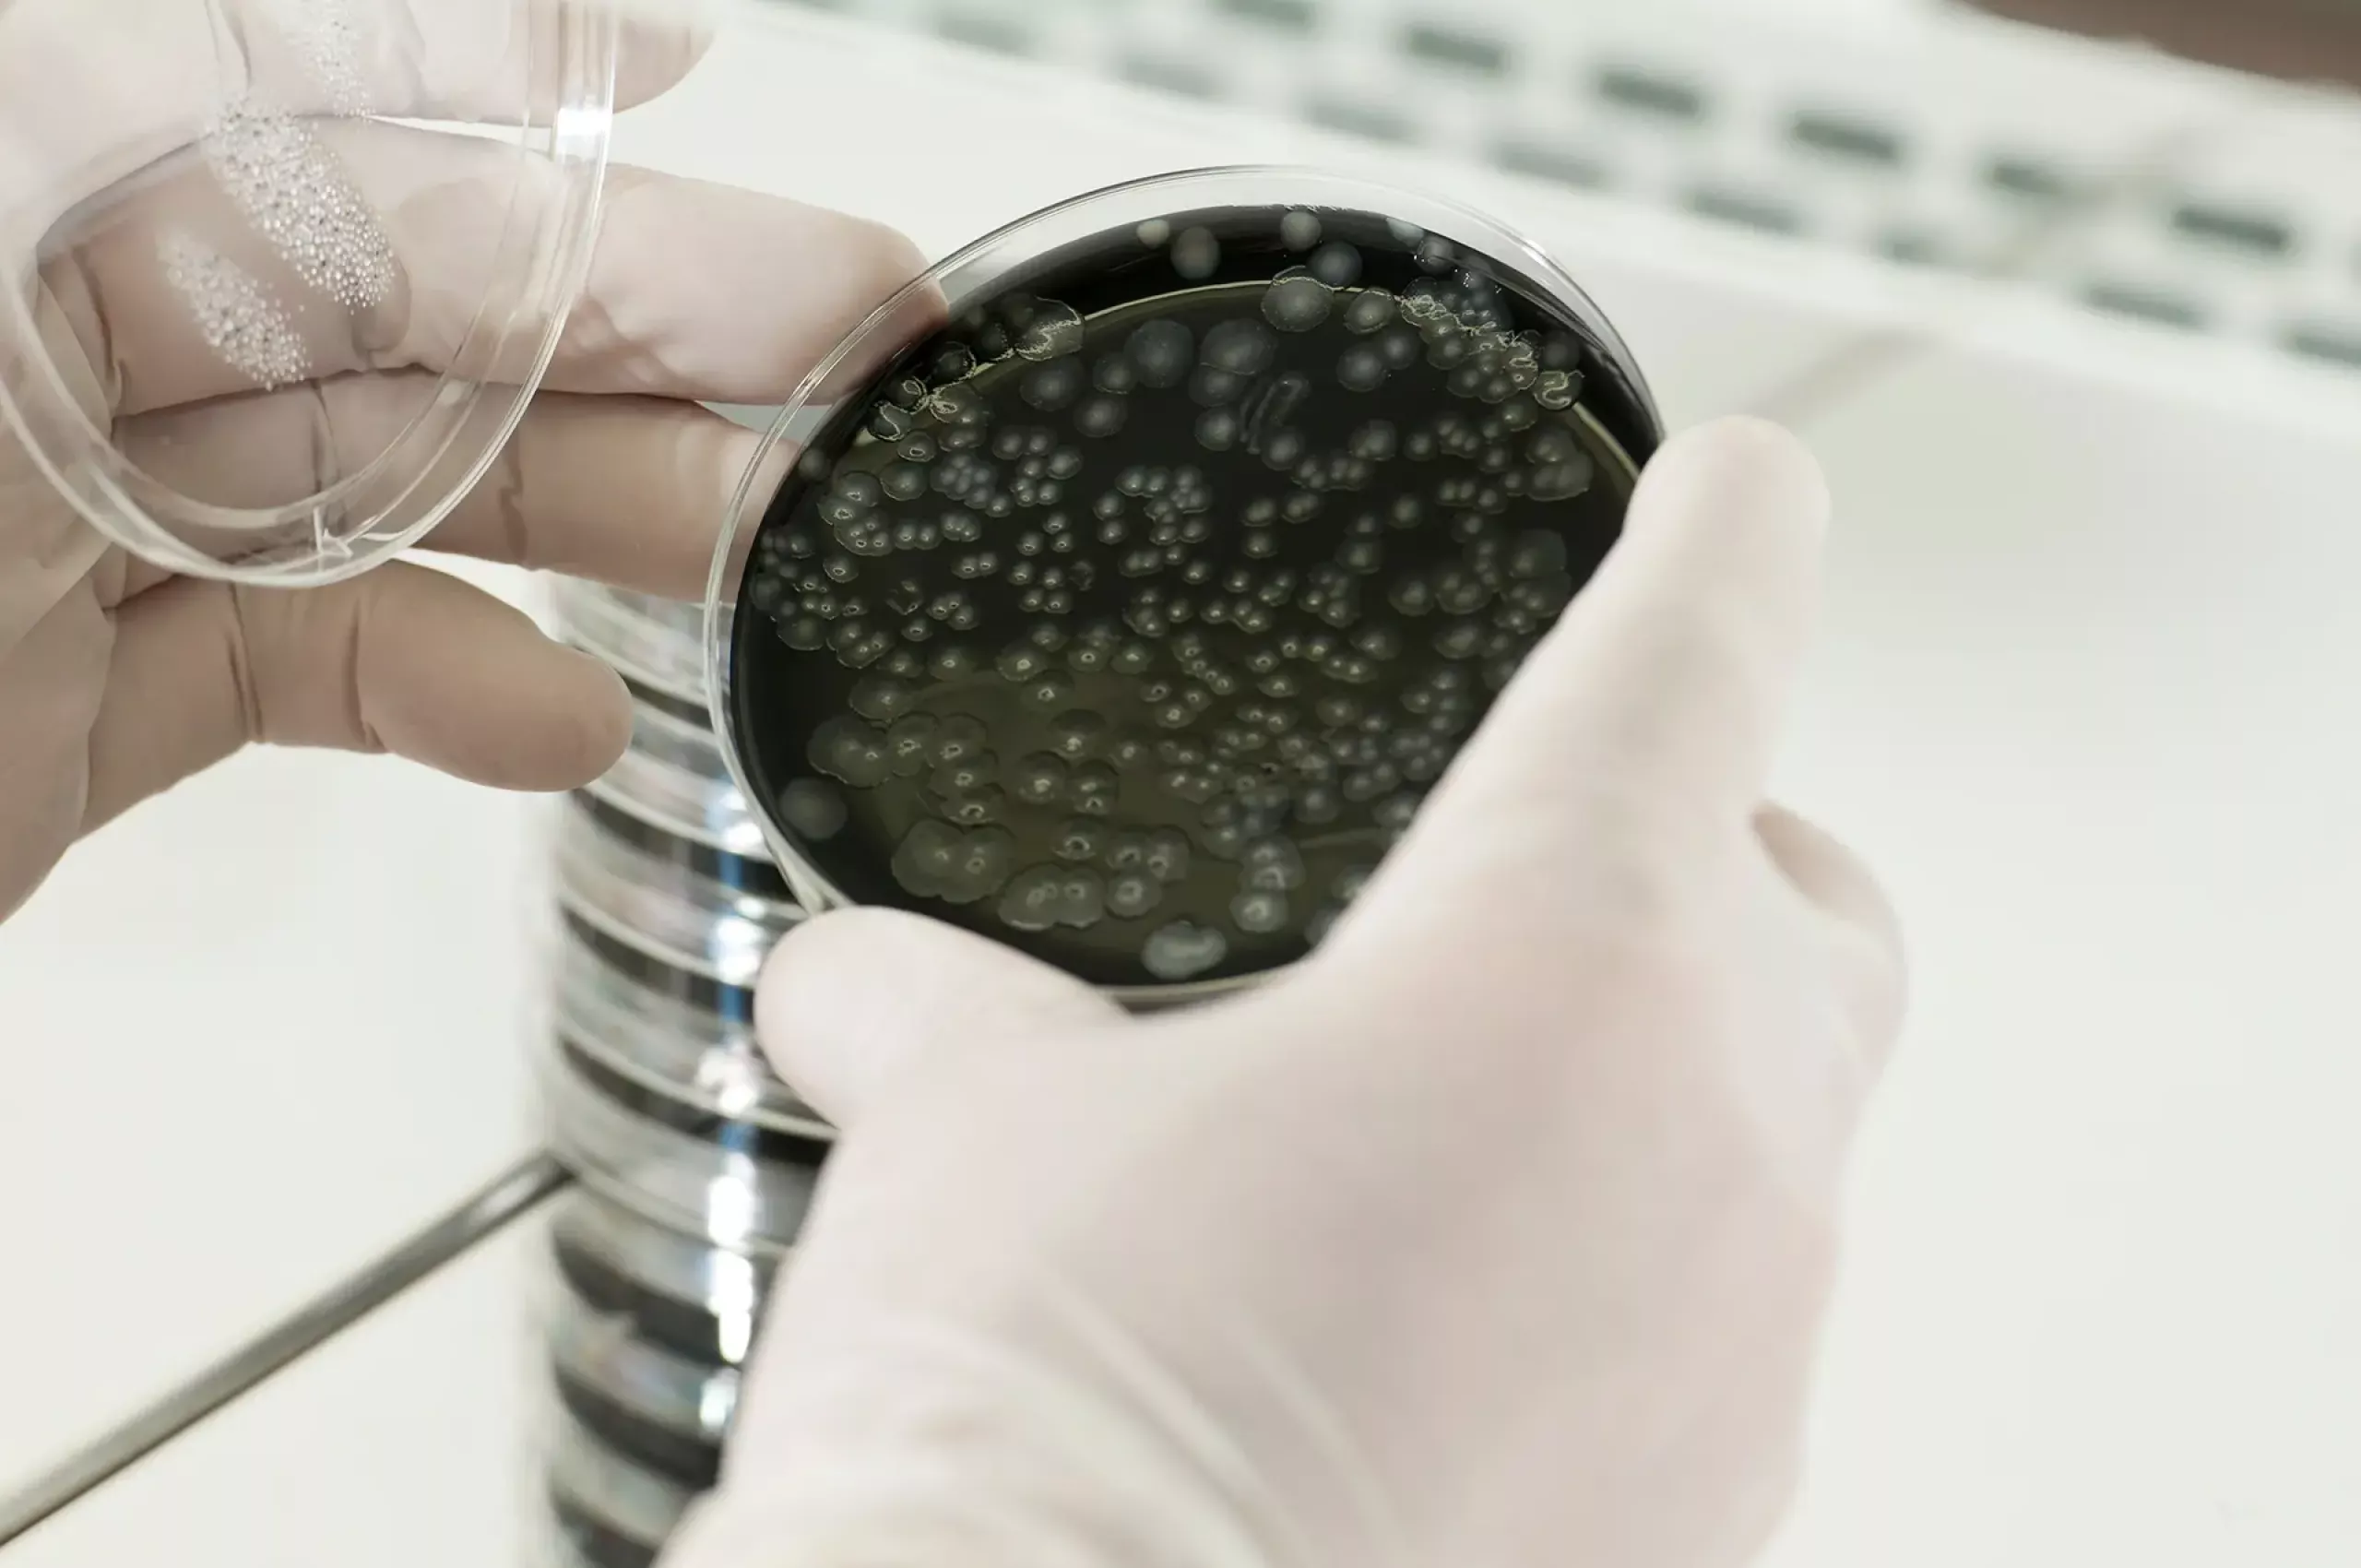

-
 Ihr Ansprechpartner für
Ihr Ansprechpartner fürLegionellenmanagement
Allgemeines zu Legionellen im Trinkwasser
Rechte und Pflichten gemäß TrinkwasserVerordnung ( TrinkwV)
Gemäß Trinkwasserverordnung müssen Inhaber von Großanlagen zur Trinkwasserversorgung, die im Rahmen einer gewerblichen Tätigkeit
Trinkwasser abgeben, Anlagen mindestens alle 3 Jahre einer Legionellenuntersuchung unterziehen (§14 Abs.3 TrinkwV ).
Erstmalig bis zum 31.12.2013 und aktuell dann bis zum 31.12.2019.
Als Großanlagen gelten Warmwasser- Installationen mit einem Speicherinhalt >400 Ltr. Volumen oder Warmwasserleitungen mit einem Inhalt von mehr als 3 Litern in mindestens einer Rohrleitung zwischen Abgang des Trinkwassererwärmers und der weitest entferntesten Entnahmestelle. Nicht berücksichtigt wird der Inhalt einer Zirkulationsleitung.
Entsprechende Anlagen in Ein- und Zweifamilienhäusern (die nur in der Familie genutzt werden und nicht zur Vermietung dienen) sind davon ausgenommen.

-
Ihr Ansprechpartner für
Ihr Ansprechpartner fürLegionellenmanagement
Legionellenmanagement
Allgemeines zu Legionellen im Trinkwasser
Rechte und Pflichten gemäß TrinkwasserVerordnung ( TrinkwV)
Gemäß Trinkwasserverordnung müssen Inhaber von Großanlagen zur Trinkwasserversorgung, die im Rahmen einer gewerblichen Tätigkeit
Trinkwasser abgeben, Anlagen mindestens alle 3 Jahre einer Legionellenuntersuchung unterziehen (§14 Abs.3 TrinkwV ).
Erstmalig bis zum 31.12.2013 und aktuell dann bis zum 31.12.2019.
Als Großanlagen gelten Warmwasser- Installationen mit einem Speicherinhalt >400 Ltr. Volumen oder Warmwasserleitungen mit einem Inhalt von mehr als 3 Litern in mindestens einer Rohrleitung zwischen Abgang des Trinkwassererwärmers und der weitest entferntesten Entnahmestelle. Nicht berücksichtigt wird der Inhalt einer Zirkulationsleitung.
Entsprechende Anlagen in Ein- und Zweifamilienhäusern (die nur in der Familie genutzt werden und nicht zur Vermietung dienen) sind davon ausgenommen.

Spezialitäten
Spezialitäten
Ziel
…Trinkwasser muss so beschaffen sein, dass durch seinen bestimmungsgemäßen Gebrauch eine Schädigung der Gesundheit insbesondere durch Krankheitserreger nicht zu erkennen ist (Auszug aus §4 Abs.1 TrinkwV). Häufig sind Legionellen, die in den nicht ausreichend dimensionierten Rohrleitungen sich entwickeln, Auslöser. Dazu kommt noch, das immer neue, wiederkehrend auch vom Versorger kostenfrei nachgeliefert werden.
Zu niedrig eingestellte Warmwasserinstallationen sind optimale Brutstätten für Legionellen (30°C bis 45°C ). Dazu kommen noch die häufig, heute zu großdimensionierten Rohrleitungen und Stagnationsbereiche ( ehemalige Wasserzuleitung zu Handwaschbecken).
DVGW W 551- Das Arbeitsblatt des DVGW schreibt vor, wann und wo auf Legionellen zu prüfen ist. Neben dem Speicher Ausgang und der Zirkulation muss an jeder endständigen Leitung eine Probe entnommen werden. Dabei müssen die Temperaturen am Speicher Ausgang 60°C und am Wiedereintritt 55 °C erreichen. Nur dann kann eine Anlage betriebssicher betrieben werden.
Maßnahmenüberschreitung – Grenzwerte
Der technische Maßnahmenwert liegt bei >100KBE / Legionella spp.je 100 ml.
Eine Überschreitung oder Erreichen des Maßnahmenwertes verpflichtet den Betreiber bzw. Inhaber der Anlage, diese unverzüglich dem Gesundheitsamt anzuzeigen und entsprechende Maßnahmen einzuleiten (§16 Abs.1 Nr. 1 u.Abs.7 TrinkwV )
Eine Unterschreitung des Maßnahmewertes bleibt ohne Konsequenzen und wird entsprechend den dazu passenden Intervall, wieder im Turnus überprüft.
Der Betreiber ist dazu verpflichtet die Ursache zu ermitteln und kurz, wie auch langfriste Maßnahmen zu ergreifen.
Die Erstellung einer Gefährdungsanalyse nach der VDI 6023 wird bei einer Grenzwertüberschreitung gefordert und dient der konkreten Feststellung von planerischen, bautechnischen und betriebsbedingten Mängeln an der Anlage. Diese müssen dann abgestellt und behoben werden um die Anlage nach den aktuellen Regeln der Technik betreiben zu können. Hier gibt es an keinem Mangel ein Bestandsschutz.